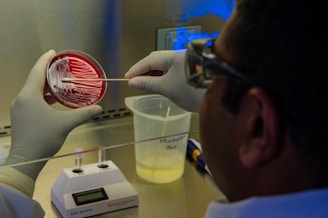

Pharmaceutical Laboratory Solutions
Consult MicroBio's




Sterility Testing Pump
The sterility pump plays a key role in the Sterility test-membrane filtration method, as it applies positive pressure to transmit the liquid sample to the canister, thereby ensuring efficient filtration under positive pressure.


Anaerobic Jar 3.5 Litres with Pressure Gauge
Air Sampler
An Air Sampler is used in active air sampling, which is utilized to verify the environmental condition of manufacturing and surrounding area. Used in Pharma, Food manufacturing area, and hospitals operation theatre to monitor environmental condition to get better control in contamination control strategy.
Pharmaceutical Laboratory Offerings


Anaerobic Gas Generation Sachet 3.5 Litres


Anaerobic Indicator (Methylene Blue)
An Anaerobic Indicator (Methylene Blue) is used in conjunction with an anaerobic gas generation sachet and anaerobic container. It is used to check whether the anaerobic condition has been maintained

QC Organisms/ Reference Cultures
QC Organisms or reference cultures are utilized for the Growth Promotion Test (GPT), Antimicrobial Effectiveness Test (AET), method validation, and disinfectant study. These organisms are used in Pharma, Food, and clinical applications.


Cell Culture Media


Anaerobic Gas Generation Sachet 3.5 Litres, Intended Use: Place the Anaerobic Gas Generation sachet in an anaerobic container, it absorbs oxygen and maintains carbon dioxide which provides an ideal environment for Anaerobic organisms
Cell culture media is utilized for mammalian tissue/cell culture, offering a wide range of media to support the growth of various cell lines under laboratory conditions.
Cell Culture flasks Treated/Untreated


Bactobank
Bactobank is microbial culture preservation system that can preserve your microbial strains. Now simplify and Ease your Microbial Culture Preservation. Contact us for more details.


Sterilized Filtration unit
Ready to use Filtration units for Microbial Enumeration (Gamma Sterilized). With application in water analysis, Pharmaceuticals assays, Food & beverages analysis etc.
Anaerobic 3.5 Litres jar are meant to contain the anaerobic condition inside the jar. Made of Polycarbonate body makes the jar unbreakable and see through so that the growth of anaerobic microbes can be monitored in real-time. Provided with a Petridish and test tube holder helps user to incubate to petridish of 90mm and test tubes easily.
ATOMSPHERE GENERATION SYSTEM


Microbiology Culture Media
Microbiology Culture Media includes Dehydrated Culture Media and Ready to Use Media. These are used for Microbiological assays and play a key role in Quality Control
